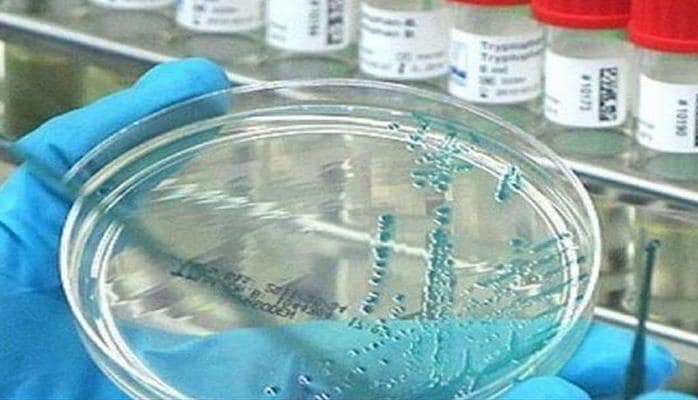
Dünyanı düşündürən sual: Peyvənd vacibdirmi?

Müəllif: Gunel Mammadova
Müəllif: Gunel Mammadova
Müəllif: Nuranə Namazova
Müəllif: Nuranə Namazova
Müəllif: Nuranə Namazova